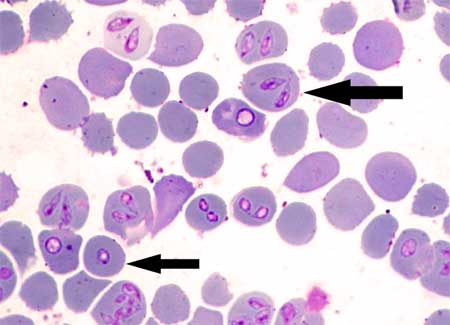
babeszjoza

Babeszje to małe pasożyty oddziaływujące na czerwone krwinki, co w konsekwencji powoduje rozwój choroby zwanej babeszjozą. Infekcja pasożytnicza jest zwykle przenoszona przez ugryzienie kleszcza i często występuje w tym samym czasie co borelioza. Jak się przed nią ustrzec, jakie są jej pierwsze objawy i jak wygląda leczenie?
Rozmaz krwi obwodowej. Okrągłe obiekty to czerwone krwinki i wewnątrz nich pasożyty babeszjozy.
Babeszjoza nazywana również piroplazmozą lub babezjozą rozprzestrzenia się przez ukąszenie zainfekowanego kleszcza (Ixodes scapularis). Może również zostać przeniesiona przez przetoczenie skażonej krwi i prawdopodobnie z chorej matki na dziecko w czasie ciąży lub porodu. Pasożyty namnażają się w krwioobiegu i niszczą przez to czerwone krwinki.
Nasilenie objawów babeszjozy może być różne i bardzo często w początkowym stadium jest ona mylona z grypą. Niekiedy chory nie odczuwa żadnych dolegliwości, a jednak niektóre przypadki mogą być na tyle poważne, że stwarzają zagrażające życiu komplikacje.
ciągłe zmęczenie,
silny ból głowy,
bóle mięśni,
bóle stawów,
ból brzucha,
nudności,
zażółcenie skóry i oczu,
zmiany nastroju.
W miarę postępu infekcji może rozwinąć się ból klatki piersiowej lub bioder, duszność i obfite poty. Możliwe jest zakażenie i brak jakichkolwiek objawów. Nawracająca wysoka gorączka jest czasem oznaką niezdiagnozowanej babeszjozy.
bardzo niskie ciśnienie krwi,
problemy z wątrobą,
Czytaj również: Neuroborelioza leczenie szpitalne
Największym problemem jest to, że babeszjoza może być trudna do zdiagnozowania i bardzo często jest mylona z innymi chorobami. Nie ma bowiem jednego schematu rozwoju, więc pojawienie się objawów oraz ich nasilenie jest różne u wszystkich pacjentów. We wczesnych stadiach pasożyty można wykryć przez badanie próbki krwi pod mikroskopem. Jednak ta metoda jest niezawodna tylko w pierwszych dwóch tygodniach infekcji.
W przypadku podejrzenia babeszjozy lekarz może przeprowadzić dalsze badania, takie jak testy immunofluorescencyjne pośrednie (IFA) lub diagnostykę molekularną – w tym przypadku jest to reakcja łańcuchowa polimerazy (PCR).
Zobacz także inne choroby i tematy związane z kleszczami:
Babeszje są pasożytami i nie reagują na antybiotyki. Nie można też pozbyć się ich domowymi medykamentami. Leczenie wymaga leków przeciwpasożytniczych, takich jak te stosowane w malarii. Lekarze najczęściej przypisują atowakwon i azytromycynę, które zwykle przyjmuje się od 7 do 10 dni. Klindamycyna w połączeniu chininą stosowana jest w cięższych przypadkach, a niekiedy wymagana jest nawet hospitalizacja.
Profilaktyka babeszjozy jest prosta, a ochrona przed ugryzieniem kleszczy jest najlepszym sposobem jej zapobiegania. Jeśli wybierasz się do obszarów zalesionych i łąkowych, szczególnie w okresie największej aktywności kleszczy (gdy temperatura wzrasta powyżej 5oC,), podejmij środki zapobiegawcze:
stosuj skuteczne środki na kleszcze,
załóż długie spodnie i koszule z długimi rękawami. Wsuń nogawki w skarpetki i nie odwijaj rękawów, gdyż kleszcz może ulokować się między fałdami materiału,
po przyjściu ze spaceru dokładnie obejrzyj całe swoje ciało. Delikatnie przejedź dłonią po powierzchni skóry i szukaj niewielkich wybrzuszeń.
Pamiętaj o tym, że kleszcz musi wgryź się w skórę, zanim będzie mógł przenieść chorobę. Mocowanie zwykle trwa kilka godzin po tym, jak kleszcz dotknie Twojej skóry lub ubrania. Nawet jeśli się już przyczepi, upłynie trochę czasu, zanim pasożyty z jego organizmu znajdą się w Twoim krwioobiegu. Masz więc 36-48 godzin, aby zacząć działać i ustrzec się przed chorobą. Jeśli nie umiesz lub nie chcesz samodzielnie wyrywać kleszcza (Ważne! Niewłaściwie usunięcie kleszcza grozi niebezpiecznymi powikłaniami!), to zgłoś się do najbliższej poradni, kliniki lub szpitala. Tam zostanie udzielona Ci odpowiednia pomoc.

Uwaga!